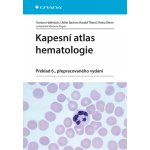
Kapesní atlas hematologie – Sleviste.cz

Skvělá kniha, která je určena mladým lékařům, hematologům, internistům, laborantům ale i medikům. Obsahuje všechna hematologická onemocnění s jejich typickými nálezy, poučení k typickým znakům a didaktické návody k vyobrazením. Čtenář v ní najde praktické návody, jak odlišit ještě „normální“ od patologického a obeznámí se i s technikami a technickými metodami vyšetřování (např. barvením, cyto-chemií, imuno-cytologií apod.). Barevná, bohatě ilustrovaná publikace obsahuje na 300 obrázků a tabulek!... Celý popis
Koupit za 640 Kč- Nejoblíbenější
- Nejlevnější
- Nejdražší

Kapesní atlas hematologie - kolektiv autorů,Torsten Haferlach
Doprava:
30 Kč
Skladem

Kapesní atlas hematologie
Doprava:
37 Kč
Skladem

Kapesní atlas hematologie Torsten Haferlach 2014
Doprava:
49 Kč
Skladem

Kapesní atlas hematologie
Doprava:
115 Kč

Kapesní atlas hematologie
Doprava:
42 Kč
Skladem
Popis
Skvělá kniha, která je určena mladým lékařům, hematologům, internistům, laborantům ale i medikům. Obsahuje všechna hematologická onemocnění s jejich typickými nálezy, poučení k typickým znakům a didaktické návody k vyobrazením. Čtenář v ní najde praktické návody, jak odlišit ještě „normální“ od patologického a obeznámí se i s technikami a technickými metodami vyšetřování (např. barvením, cyto-chemií, imuno-cytologií apod.).
Barevná, bohatě ilustrovaná publikace obsahuje na 300 obrázků a tabulek! Přeloženo z německého originálu „Taschematlas Hämatologie“, který vydalo v roce 2012 nakladatelství Thieme Verlag v již 6., přepracovaném vydání.
Barevná, bohatě ilustrovaná publikace obsahuje na 300 obrázků a tabulek! Přeloženo z německého originálu „Taschematlas Hämatologie“, který vydalo v roce 2012 nakladatelství Thieme Verlag v již 6., přepracovaném vydání.
Parametry
| Žánr | odborné |
| Rok vydání | 2014 |
| Nakladatelství | Grada |
| Autor | Torsten Haferlach |
| Počet stran | 232 |
| Výrobce | Grada |
| Vazba | vázaná |
| Jazyk | české |
| Váha | 322 gramů |
| ISBN | 978-80-247-4787-3 |